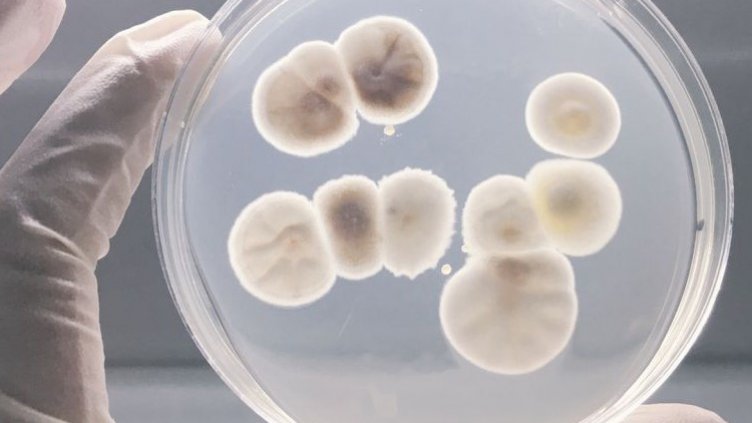
СЗО бие тревога за 12 особено опасни бактерии

Световната здравна организация (СЗО) публикува списък с 12 семейства бактерии, срещу които спешно трябва да се разработят нови антибиотици. Списъкът е съставен, за да се популяризират изследванията за създаване на нови антибиотици, се казва в комюнике на СЗО. Целта е да се попречи на появата на нови нелечими инфекциозни заболявания, съобщиха световните информационни агенции, цитирани от БТА.
Рискът е преценен като критичен, що се отнася до три семейства бактерии - Acinetobacter, Pseudomonas и ентеробактериите, сред които Ешерихия коли, които са резистентни към най-новите антибиотици. "Резистентността към антибиотиците нараства и терапевтичните опции бързо се изчерпват", предупреди експертът Мари-Пол Киени от СЗО. Като свой висок приоритет СЗО определи 6 семейства патогенни агенти, сред които златистият стафилокок, бактериите, причиняващи салмонелоза, и хеликобактер пилори.

Рекорд на Гинес: 256 км без завой по Магистрала 10 в Саудитска Арабия
Рекорд на Гинес: 256 км без завой по Магистрала 10 в Саудитска Арабия  Русия: Франция не допринася за каузата на мира
Русия: Франция не допринася за каузата на мира  Ученик дари парите от рождения си ден за благотворителна кауза за Коледа
Ученик дари парите от рождения си ден за благотворителна кауза за Коледа  Путин за "Сталинград": Русия единствена в света произвежда ядрени ледоразбивачи
Путин за "Сталинград": Русия единствена в света произвежда ядрени ледоразбивачи 
 Дефицит на две вещества може да доведе до развитието на зрително увреждане
Дефицит на две вещества може да доведе до развитието на зрително увреждане  Франция ще тества в орбита спасителен скафандър за бъдещ пилотиран кораб
Франция ще тества в орбита спасителен скафандър за бъдещ пилотиран кораб  НАСА представя материали за 3I/ATLAS на специален брифинг: Какво да очакваме
НАСА представя материали за 3I/ATLAS на специален брифинг: Какво да очакваме  Vega C ще изведе в орбита южнокорейския KOMPSAT-7 на 28 ноември
Vega C ще изведе в орбита южнокорейския KOMPSAT-7 на 28 ноември 
 Пеп вижда нещо в него: Сити троши 100 млн. евро за турчин от Реал
Пеп вижда нещо в него: Сити троши 100 млн. евро за турчин от Реал  Ван Дайк строши голям рекорд на Франк де Бур
Ван Дайк строши голям рекорд на Франк де Бур  Гутева свири на Рома в Шампионската лига, Гидженов ще помага!
Гутева свири на Рома в Шампионската лига, Гидженов ще помага!  БФС глоби три клуба заради бесните им фенове
БФС глоби три клуба заради бесните им фенове 
 10 постни рецепти за Деня на семейството
10 постни рецепти за Деня на семейството  Нумерологична прогноза за 2026 година
Нумерологична прогноза за 2026 година  Шоколадов тарт без печене и без захар
Шоколадов тарт без печене и без захар  Beverly Hills Polo Club: Спортен шик за есента
Beverly Hills Polo Club: Спортен шик за есента 
 Карфиолът предпазва от рак и помага при отслабване
Карфиолът предпазва от рак и помага при отслабване  Балканска нефропатия – ендемично заболяване водещо до бъбречна недостатъчност
Балканска нефропатия – ендемично заболяване водещо до бъбречна недостатъчност  Масло от шипка и ползите му за здравето
Масло от шипка и ползите му за здравето  450 абсолвенти от Випуск 2025 на Факултета по обществено здравеопазване получиха дипломите си на тържествена церемония във Варна
450 абсолвенти от Випуск 2025 на Факултета по обществено здравеопазване получиха дипломите си на тържествена церемония във Варна 
 дава под наем, Тристаен апартамент, 100 m2 София, Хаджи Димитър, 520 EUR
дава под наем, Тристаен апартамент, 100 m2 София, Хаджи Димитър, 520 EUR  дава под наем, Двустаен апартамент, 100 m2 София, Хаджи Димитър, 520 EUR
дава под наем, Двустаен апартамент, 100 m2 София, Хаджи Димитър, 520 EUR  дава под наем, Двустаен апартамент, 100 m2 София, Суха Река, 520 EUR
дава под наем, Двустаен апартамент, 100 m2 София, Суха Река, 520 EUR  дава под наем, Тристаен апартамент, 100 m2 София, Суха Река, 520 EUR
дава под наем, Тристаен апартамент, 100 m2 София, Суха Река, 520 EUR 












 Пореден срив: Проблем с Cloudflare спря достъпа до множество сайтове по света и у нас
Пореден срив: Проблем с Cloudflare спря достъпа до множество сайтове по света и у нас  Русия: Франция не допринася за каузата на мира
Русия: Франция не допринася за каузата на мира  Пазарът на облигации няма да спаси британския премиер или неговия финансов министър
Пазарът на облигации няма да спаси британския премиер или неговия финансов министър  Регенерираните гуми набират популярност. По-евтини, но дали са безопасни?
Регенерираните гуми набират популярност. По-евтини, но дали са безопасни?  След Ерик Дейн – още един актьор от „Анатомията на Грей“ е диагностициран с тежко заболяване
След Ерик Дейн – още един актьор от „Анатомията на Грей“ е диагностициран с тежко заболяване  Дженифър Анистън съжалява, че Матю Пери не е намерил щастието
Дженифър Анистън съжалява, че Матю Пери не е намерил щастието
Коментари